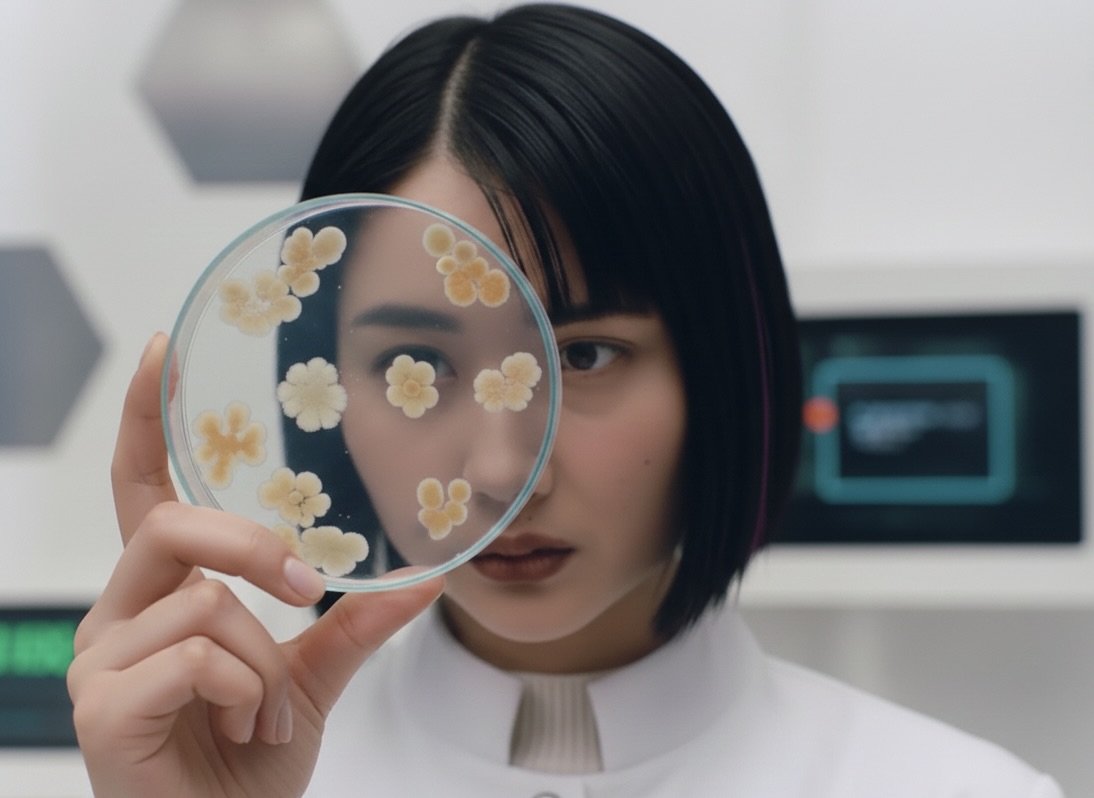
A woman with short black hair holds a magnifying glass close to her face, examining something intently.

Nicht raten, einfach testen.
Nimm deine Intimgesundheit selbst in die Hand.
femote vereint Wissenschaft, Komfort und Fürsorge, damit du deine Gesundheitsprobleme schnell, diskret und effektiv – direkt von zuhause aus – lösen kannst. Wir starten mit Intiminfektionen, aber unser langfristiges Ziel ist es, die medizinische Forschung voranzubringen.
Klopf, Klopf!
Hilfe für deine Intimgesundheit wo immer du bist.
🦪
Klopf, Klopf! Hilfe für deine Intimgesundheit wo immer du bist. 🦪
Unsere Mission.
Jeden Datenpunkt den du teilst, verbessert nicht nur deine eigene Behandlung, sondern ermöglichen auch die Forschung für die Zukunft. Je mehr wir zusammen lernen, desto größer unser Einfluss auf die weibliche Gesundheitsversorgung.
Nie wieder warten.
Hilfe bei deiner Intiminfektion in drei einfachen Schritten.
Teste zuhause.
01. GESUNDHEIT, WANN ES DIR PASST
Erhalte zuverlässige Ergebnisse mit unseren schnellen, antigenbasierten Tests – in nur 15 Minuten.
02. MEDIZINISCHE UNTERSTÜTZUNG SPEZIELL FÜR DICH
Digitales Arztgespräch
Erhalte individuelle Empfehlungen und Behandlungen von unserem vertrauenswürdigen Netzwerk aus Fachärzt:innen.
Fühl dich verbunden
03. DU BIST NICHT ALLEIN
Tausche dich mit anderen in unserer Community aus, die ebenfalls ihre Intimgesundheit in die Hand nehmen.
Sei als erste dabei.
Mit der Eingabe deiner E-Mail-Adresse akzeptierst du die Datenschutzerklärung dieser Webseite.
-

⚡️ Schnell.
Expressversand innerhalb von 24 Stunden in Deutschland. Testergebnisse in nur 15 Minuten. Rezepte innerhalb weniger Stunden.
-

👀 Diskret.
Keine unangenehmen Gespräche oder Zuhörer. Kümmere dich um deine Intimgesundheit, wann und wo du dich sicher fühlst.
-
🩺 Sicher.
Unsere Tests sind CE-zertifiziert, die App folgt aktuellen Sicherheitsstandards für maximalen Datenschutz, und alle Inhalte werden ärztlich geprüft.
Zuverlässige Ergebnisse, einfache medizinische Beratung & Community: Alles in einer Box.
-
Leider kannst du unsere Tests derzeit noch nicht direkt kaufen, da wir noch nicht offiziell gestartet sind. Du kannst dich jedoch für unser Beta-Programm und Warteliste anmelden. In Zukunft wirst du unsere Tests in unserem Onlineshop und hoffentlich auch in einem Geschäft in deiner Nähe finden.
-
Du kannst dir den Test ähnlich wie einen Covid-Selbsttest vorstellen, mit dem einzigen Unterschied, dass femote-Tests eine Urin- oder Vaginalsekretprobe verwenden. Sammle einfach eine Probe, tropfe sie auf den Test und warte 15 Minuten.
-
Unsere Standardtests sind Schnelltests, die dir innerhalb von 15 Minuten ein Ergebnis liefern – egal, wo du bist.
-
Unsere App führt dich durch jeden Schritt. Wenn du ein positives Testergebnis erhältst, bieten wir dir eine nahtlose Lösung, um verschreibungspflichtige Medikamente anzufordern oder eine Videokonsultation zu buchen. Außerdem erhältst du alle Informationen, die du brauchst, um die beste Behandlung für dich zu finden.
-
Bei einem positiven Testergebnis kannst du eine Videosprechstunde mit einem Arzt oder einer Ärztin aus unserem Netzwerk buchen. Falls nötig, stellen sie ein Rezept aus, das du entweder in einer Apotheke deiner Wahl einlösen oder direkt über einen unserer Online-Apothekenpartner bestellen kannst.
Hört sich gut an?
Sei von Anfang an dabei!
UNSERE MISSION MIT DIR
Intimgesundheit. Digital neu gedacht.
Wir wissen aus eigener Erfahrung, wie es ist, für die eigene Gesundheit kämpfen zu müssen. Es ist anstrengend, zeitaufwändig und viel zu oft nicht erfolgreich. Deshalb haben wir gesagt: “Gut, dann machen wir es eben selbst!” und femote gegründet.
Jetzt kannst du deine Intimgesundheit ganzheitlich von zu Hause aus behandeln – mit Ärzt:innen, die deine Situation verstehen und dich ernst nehmen.
Wir nehmen Intimgesundheit ernst. Du auch?
Ich habe für Vaginalpilz meinen Job gekündigt…
Hi, ich bin Frederike, Gründerin von femote – und vermutlich die Frau mit den öffentlichsten Intiminfektionen in Deutschland. Spaß beiseite: Ich habe selbst jahrelang mit wiederkehrenden Beschwerden gekämpft. Aus dieser Frustration als Patientin, meinem langen Weg zur Besserung und meinem fachlichen Hintergrund in Digital- und Datenstrategien entstand femote.
Also ja, wenn man so will: Ich habe für Vaginalpilz meinen Job gekündigt.
Seitdem ist meine Mission größer geworden als nur „schnellere Hilfe bei Infektionen“. Ich möchte gemeinsam mit euch die gynäkologische Versorgung des 21. Jahrhunderts bauen – digital, ortsunabhängig, persönlich und empowernd. Eine Versorgung, an der Patient:innen und Ärzt:innen wirklich mitgestalten.
Mehr zu meiner Geschicht findest du hier:
Wir nehmen Intimgesundheit ernst. Du auch?
Deine Intimgesundheit sagt viel über deine allgemeine Gesundheit aus. Deshalb solltest du Beschwerden oder ungewöhnliche Veränderungen nie ignorieren.
femote und unser Netzwerk aus Ärzt:innen helfen dir dabei, deinen Intimgesundheitsstatus bequem von zu Hause aus zu bestimmen. Egal, ob es um akute Symptome wie bakterielle Vaginose, Pilzinfektionen oder Blasenentzündungen geht – oder einfach darum, sicherzustellen, dass alles im Gleichgewicht ist. Wir sind für dich da.
29 % der Menschen mit einer Vagina sind innerhalb eines Jahres von bakterieller Vaginose betroffen, 15 % von einer Pilzinfektion und 11 % von einer Blasenentzündung.